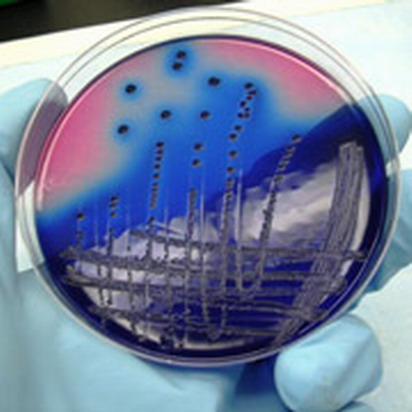

|
|
|
|
|
|
|
|
无所不在的Escherichia coli细菌有理由被认为是最成功的细菌变种,美国南加利福尼亚大学的史蒂文•芬克尔博士还找到了另一个理由,他发现Escherichia coli细菌可以平安地吃光自己竞争对手的DNA,即DNA是Escherichia coli细菌可以接受的营养源。
无所不在的Escherichia coli细菌有理由被认为是最成功的细菌变种,美国南加利福尼亚大学的史蒂文•芬克尔博士还找到了另一个理由,他发现Escherichia coli细菌可以平安地吃光自己竞争对手的DNA,即DNA是Escherichia coli细菌可以接受的营养源。
芬克尔博士指出,比自己同类活得更长久的细菌能一举两得:不仅可以不再为食物而战,而且还能大大增加自己的营养。实际上细菌互相吃光DNA,它们能利用DNA作为唯一营养源,酸仍然是细菌的备用营养物质,因为“咬碎”酸比咬碎葡萄糖或其他简单营养物质更困难。
芬克尔博士将自己的研究现象称之为“营养能力”,这时细胞同化非必需DNA以便改变或恢复自己的染色体组。研究人员找到Escherichia coli细菌“营养能力”必需的8种基因,它们能使细菌安全地吃光DNA。缺少其中任何一种基因,细菌都不能吃光DNA,便会失去竞争优势。
芬克尔博士认为,利用DNA作为营养物质
< 1 > < 2 >
|
|
|
|
|
设为首页 | 加入收藏 | 广告服务 | 友情链接 | 版权申明
Copyriht 2007 - 2008 © 科普之友 All right reserved |